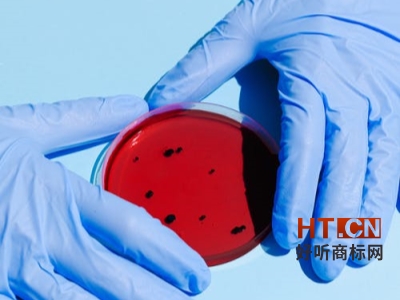
商标转让

时间:2020-09-21
京东首关
商标类型:中文
有效期限:2020-05-13
商标交易类型:商标转让
类似群组:3301
适用于:烧酒 葡萄酒 酒(利口酒) 含水果的酒精饮料 威士忌酒 黄酒 开胃酒 米酒 料酒 清酒
入驻电商: 天猫 京东 亚马逊 1号店 蘑菇街
京东首关品牌转让简表
以上就是好听网商标网为您介绍的关于 京东首关商标转让的相关资讯。想要了解更多 京东首关品牌转让的信息,请登陆好听网商标网商标商城在线免费咨询。专业的商标顾问会给予 您详细的建议。同时您也可以致电好听网商标网全国客户服务热线:4006999467.专业的知识产权顾问将一一为您解答更多关于 京东首关品牌转让的有关问题。
好听商标网在此声明:该文章内容转载自网络,目的是服务于好听商标网用户,让其获取更多更全的关于商标知识与信息。版权归原作者所有,我们尊重原创并饱含敬意。若有不妥,请联系告知修改或删除,谢谢。